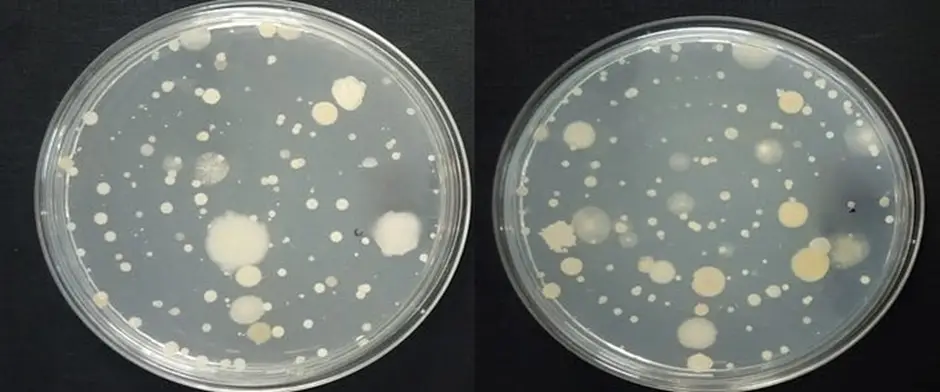
Effect of AC in air purification

Demystifying Air Conditioning
Demystifying Air Conditioning: Impacts on Indoor Air Quality
As the temperature rises with the onset of summer, the use of air conditioning becomes more prevalent. However, amidst growing concerns about indoor air quality (IAQ), many wonder about the impact of air conditioning on IAQ. Let’s debunk some common misconceptions surrounding air conditioners and delve into their actual effects on the air quality within your space.

Dispelling Common Myths:
Myth 1: Air conditioners bring outdoor air inside.
Reality: Contrary to popular belief, air conditioners don’t introduce outdoor air into your home. Instead, they circulate and cool the air already present indoors using a combination of refrigerants, fans, and evaporator coils.
Myth 2: Air conditioners purify air or filter pollution.
Reality: Air conditioners aren’t equipped to purify indoor air. Air conditioning often exacerbates indoor air pollution. By recirculating existing indoor air, it fails to address pollutants effectively. Moreover, the common practice of sealing windows and doors to enhance cooling traps indoor contaminants further.
Furthermore, poorly maintained or overused air conditioners can degrade Indoor Air Quality (IAQ), leading to health issues such as nasal congestion, itchy eyes, headaches, and respiratory discomfort. Dry cold air from AC units can exacerbate skin and respiratory problems, especially for individuals with allergies or asthma.
Dispelling Common Myths:
Taken aback by the claims put forth by manufacturers, we recently conducted a test on a commercially available air conditioner.
The Test Setup:
The test was conducted with a commercially available 1.5ton AC bought from Amazon, which claims to have “Antibacterial Filters”. A room of 140sq. ft (14ft x 10ft) with standard 10ft height was selected, the indoor unit of the AC was mounted on the wall by a professional. The temperature was maintained at 22C throughout the testing.
Experiment 01: A handheld Air Sampler coupled with Tryptic Soy Agar was used to collect airborne bacterial samples before and after operating the AC. The AC was operated for 1 hour.
Experiment 02: In another experiment, Particulate matters were generated by burning incense sticks inside the room and monitored using Sensiron SPS30. The duration of the experiment was 1 hour, samples were collected at regular intervals. PM 1, PM 2.5, PM 4, PM 10 was monitored during the entire duration.
Findings:
We were not surprised by the findings, when tested for removal of airborne bacteria, the AC showed no effect. The picture below was from the actual experiment, each dot represents a colony of bacteria (naturally present in the air) that originated from a single bacterium. Before the AC was operated, the naturally occurring bacterial load present in the air was 870CFU/m3, after operating the AC for 1 hour inside the room the bacterial load was reduced to 810CFU/m3.
Left: Airborne Bacterial load Before the AC was operated. Right: Airborne Bacterial load after the AC was operated for 1 hour.
As for particulate matters, the results were:
Mass Concentration (ugm/m3)


As observed, hardly any reduction for Particulate matter was observed across the entire spectrum of Particulate Matters.
The initial reduction of particulate matter is due the circulation and dilution phenomenon. Over the entire period, the particulate matter concentration levels were more or less constant, around 2800ugm/m3.
Our take:
We understand that giving up your Air Conditioner isn’t realistic or necessary. Instead, it’s important to recognize that an air conditioning unit alone isn’t enough to ensure healthy indoor air quality. By integrating complementary devices like Air Sterilizers we can significantly improve indoor air quality.



